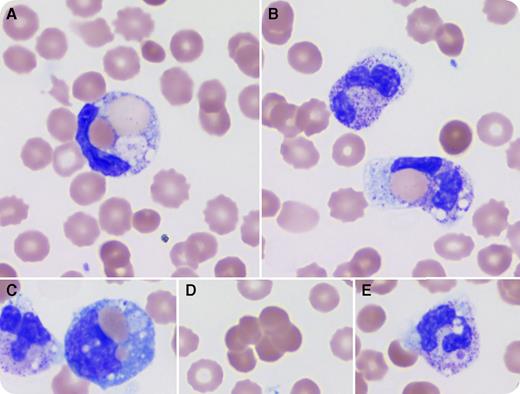
A 3-year-old boy presented with abdominal pain, fever, diarrhea, and dark urine for a few days. Complete blood count showed leukocytosis (white blood cells, 18.62 × 109/L), anemia (hemoglobin, 8.9 g/dL), and thrombocytopenia (platelets, 134 × 109/L). Lactate dehydrogenase, blood urea nitrogen, indirect bilirubin, and creatinine were increased. Hemolytic uremic syndrome (HUS) was clinically suspected based on anemia, thrombocytopenia, elevated creatinine, and diarrhea. Pathology review of the peripheral blood (PB) showed anisocytic erythrocytes with polychromasia, spherocytes, and schistocytes, increased neutrophils with left shift, toxic granulation, vacuolation, and frequent erythrophagocytosis (panels A-B; for all panels, original magnification ×1000, Wright stain). Occasional erythrophagocytosis by monocytes (panel C), red blood cell agglutination (panel D), and platelet phagocytosis by neutrophils (panel E) were also present. Based on these findings, HUS was ruled out and paroxysmal cold hemoglobinuria (PCH) was suspected. A direct antiglobulin test was immunoglobulin G negative but complement positive. The Donath-Landsteiner test was positive and confirmed the diagnosis of PCH. The patient was kept warm and treated supportively; his hemoglobin and platelet count normalized after a month. / PCH is a self-limiting hemolytic disease, but may cause severe anemia and acute kidney injury. Careful evaluation of PB smear is important for immediate recognition and proper management. Erythrophagocytosis by neutrophils is an uncommon phenomenon; its presence with suspected hemolysis should raise the concern for PCH.

A 3-year-old boy presented with abdominal pain, fever, diarrhea, and dark urine for a few days. Complete blood count showed leukocytosis (white blood cells, 18.62 × 109/L), anemia (hemoglobin, 8.9 g/dL), and thrombocytopenia (platelets, 134 × 109/L). Lactate dehydrogenase, blood urea nitrogen, indirect bilirubin, and creatinine were increased. Hemolytic uremic syndrome (HUS) was clinically suspected based on anemia, thrombocytopenia, elevated creatinine, and diarrhea. Pathology review of the peripheral blood (PB) showed anisocytic erythrocytes with polychromasia, spherocytes, and schistocytes, increased neutrophils with left shift, toxic granulation, vacuolation, and frequent erythrophagocytosis (panels A-B; for all panels, original magnification ×1000, Wright stain). Occasional erythrophagocytosis by monocytes (panel C), red blood cell agglutination (panel D), and platelet phagocytosis by neutrophils (panel E) were also present. Based on these findings, HUS was ruled out and paroxysmal cold hemoglobinuria (PCH) was suspected. A direct antiglobulin test was immunoglobulin G negative but complement positive. The Donath-Landsteiner test was positive and confirmed the diagnosis of PCH. The patient was kept warm and treated supportively; his hemoglobin and platelet count normalized after a month.
PCH is a self-limiting hemolytic disease, but may cause severe anemia and acute kidney injury. Careful evaluation of PB smear is important for immediate recognition and proper management. Erythrophagocytosis by neutrophils is an uncommon phenomenon; its presence with suspected hemolysis should raise the concern for PCH.
A 3-year-old boy presented with abdominal pain, fever, diarrhea, and dark urine for a few days. Complete blood count showed leukocytosis (white blood cells, 18.62 × 109/L), anemia (hemoglobin, 8.9 g/dL), and thrombocytopenia (platelets, 134 × 109/L). Lactate dehydrogenase, blood urea nitrogen, indirect bilirubin, and creatinine were increased. Hemolytic uremic syndrome (HUS) was clinically suspected based on anemia, thrombocytopenia, elevated creatinine, and diarrhea. Pathology review of the peripheral blood (PB) showed anisocytic erythrocytes with polychromasia, spherocytes, and schistocytes, increased neutrophils with left shift, toxic granulation, vacuolation, and frequent erythrophagocytosis (panels A-B; for all panels, original magnification ×1000, Wright stain). Occasional erythrophagocytosis by monocytes (panel C), red blood cell agglutination (panel D), and platelet phagocytosis by neutrophils (panel E) were also present. Based on these findings, HUS was ruled out and paroxysmal cold hemoglobinuria (PCH) was suspected. A direct antiglobulin test was immunoglobulin G negative but complement positive. The Donath-Landsteiner test was positive and confirmed the diagnosis of PCH. The patient was kept warm and treated supportively; his hemoglobin and platelet count normalized after a month.
PCH is a self-limiting hemolytic disease, but may cause severe anemia and acute kidney injury. Careful evaluation of PB smear is important for immediate recognition and proper management. Erythrophagocytosis by neutrophils is an uncommon phenomenon; its presence with suspected hemolysis should raise the concern for PCH.
For additional images, visit the ASH IMAGE BANK, a reference and teaching tool that is continually updated with new atlas and case study images. For more information visit http://imagebank.hematology.org.